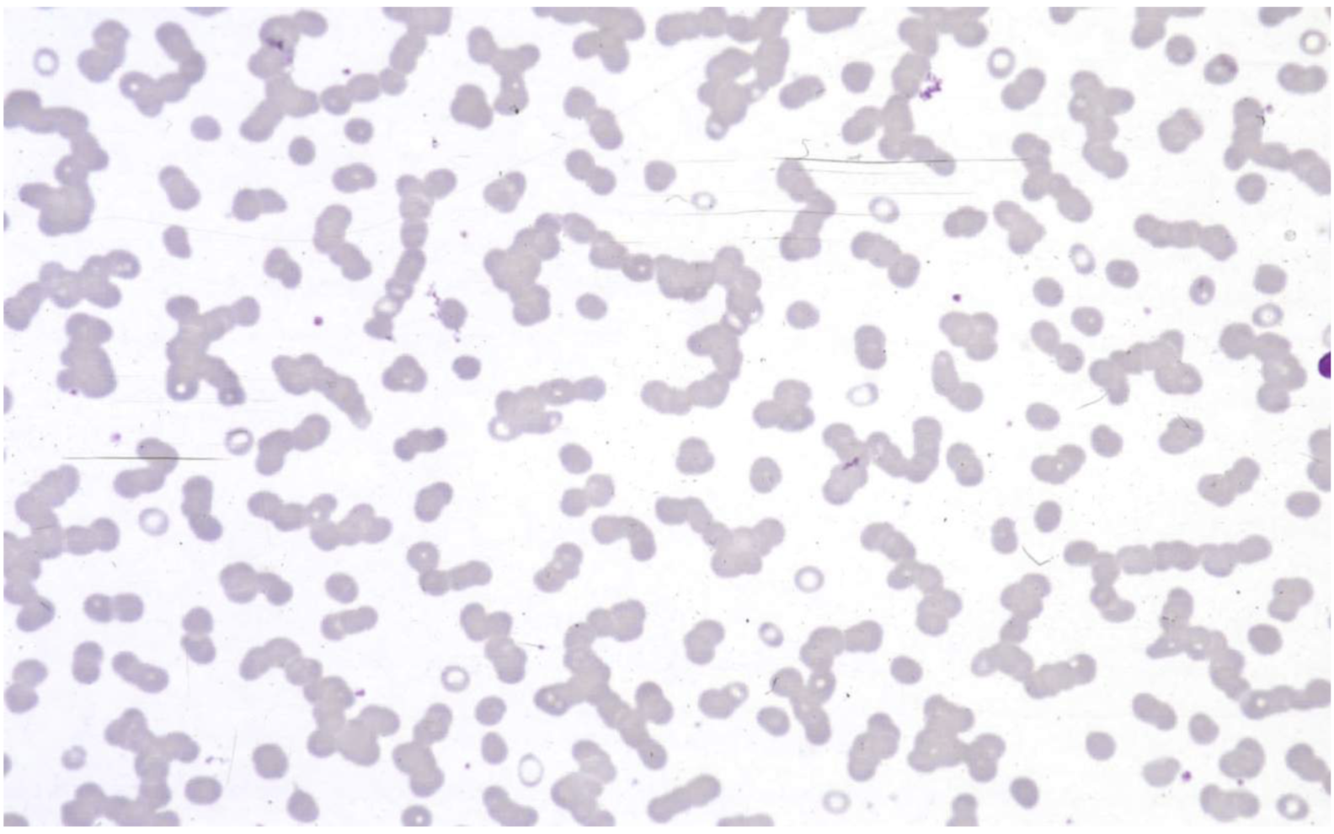

1
Q

A
Amylod heart on Congo red stain
- amyloidosis
2
Q

A
plasmacytoid lymphocytes
- waldenstrom’s
3
Q

A
waldenstrom’s
4
Q
commonly seen in

A
- multiple myeloma

Amylod heart on Congo red stain

plasmacytoid lymphocytes

waldenstrom’s
commonly seen in